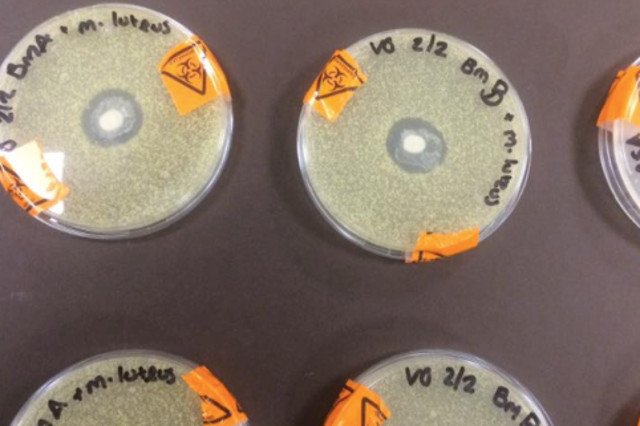
Vcky Greene jest studentką mikrobiologii.  Wykonała eksperyment, którego wyniki zachwycają matki na całym świecie.

O niezwykłych właściwościach mleka matki powiedziano już wiele. Za każdym razem jednak, kiedy pojawia się nowy dowód jego unikalnego działania, świat się zachwyca. Siła naturalnego dostosowania ciała kobiety do roli matki jest tak wyjątkowa, że nie sposób potraktować jej obojętnie.
REKLAMA
Kropla życia
Jakiś czas temu sieć obiegło nagranie młodej matki Jansen Howard, na którym widać próbkę jej mleka pod mikroskopem. Do tej pory wideo zostało wyświetlone ponad 2 mln razy. W opisie na portalu, zachwycała się życiem, które widać w kropli jej matczynego mleka i tym, jaka jest jego zdolność do dostosowywania się do potrzeb jej dziecka.
Jakiś czas temu sieć obiegło nagranie młodej matki Jansen Howard, na którym widać próbkę jej mleka pod mikroskopem. Do tej pory wideo zostało wyświetlone ponad 2 mln razy. W opisie na portalu, zachwycała się życiem, które widać w kropli jej matczynego mleka i tym, jaka jest jego zdolność do dostosowywania się do potrzeb jej dziecka.
O swoich doświadczeniach i emocjach związanych z karmieniem mówiła, że nie zawsze było dobrze i początki macierzyństwa były dla niej trudne. Jednak: "Kiedy przystawiała córkę do piersi, sztorm ucichał, a ja miałam poczucie, że wszystko jest na właściwym miejscu".
Karmienie piersią to przyszłość
Teraz sieć obiegł eksperyment studentki mikrobiologii Vicky Greene, który nie pozostawia żadnych wątpliwości–mleko matki nie ma sobie równych!
Teraz sieć obiegł eksperyment studentki mikrobiologii Vicky Greene, który nie pozostawia żadnych wątpliwości–mleko matki nie ma sobie równych!
Do dziewięciu naczyń, w których znajdowała się bakteria M. Luteus studentka dodała kroplę matczynego mleka, pobranego uprzednio od dwóch różnych matek. Wyniki były oczywiste i niezwykłe jednocześnie – białe plamy w środku płynu są dowodem na to, że mleko hamowało rozwój bakterii.
O wynikach Vicky pisze tak:
Jestem bardzo podekscytowana! Przyszłość jest jasna, przyszłość to karmienie piersią.
Właściwości bez terminu ważności
Wykorzystane mleko pochodziło od dwóch matek, dzieci w różnym wieku. Jedno z nich miało 15 miesięcy, drugie 3 lata. Mleko jednej i drugiej okazało się mieć takie same właściwości ochronne.
Wykorzystane mleko pochodziło od dwóch matek, dzieci w różnym wieku. Jedno z nich miało 15 miesięcy, drugie 3 lata. Mleko jednej i drugiej okazało się mieć takie same właściwości ochronne.
To bezsprzecznie odrzuca głosy, jakoby mleko matki traciło swoje właściwości w miarę upływu czasu. Chroni w takim samym stopniu karmionego noworodka, jak 3–latka.
Nie mieliśmy dotąd okazji, tak fizycznie zobaczyć działania matczynego mleka. Jesteśmy pod ogromnym wrażeniem.
Może cię zainteresować także: Inicjatywa krakowskiej AGH podbija serca matek. Dzięki niej odgłosy ssania trafiły na YouTube
Źródło: scarymommy.com
Napisz do autora: magda.wozniak@mamadu.pl
